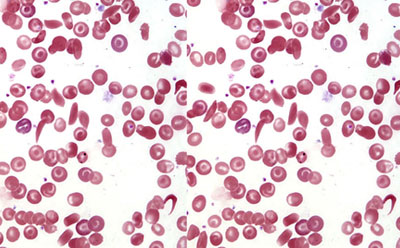

Facilities Provided
Dr. Muralidaran C specializes in providing comprehensive care for blood disorders and hematological conditions, offering advanced diagnostic and therapeutic solutions with a focus on personalized patient care.

Advanced and state-of-the-art treatments for adult hematological malignancies (blood cancers) combine cutting-edge technology, innovative therapies, and personalized approaches to ensure optimal patient outcomes.
Read More
Pediatric Hematological Malignancies Management involves the diagnosis, treatment, and supportive care of blood cancers in children, such as Acute Lymphoblastic Leukemia (ALL), Acute Myeloid Leukemia (AML), Myelodysplastic Syndromes (MDS), and Lymphomas. Management focuses on curing the disease while minimizing long-term side effects.
Read More
Benign Hematological Disorders refer to non-cancerous blood-related conditions that affect the production, function, or components of blood, including red blood cells (RBCs), white blood cells (WBCs), platelets, and plasma. These disorders can affect both adults and children, presenting as anemia, bleeding tendencies, or abnormal blood counts. Management typically involves medical therapies and supportive care to address symptoms and improve quality of life.
Read More
Clotting and bleeding disorders affect the body's ability to form clots or regulate bleeding. These conditions can result in excessive bleeding (hypocoagulable states) or abnormal clot formation (hypercoagulable states). Proper diagnosis and management are essential to prevent complications and ensure patient safety.
Read More
Bone Marrow Transplantation (BMT) is a medical procedure that replaces damaged or diseased bone marrow with healthy hematopoietic stem cells. It is commonly performed for patients with hematological malignancies, immune disorders, or other severe blood-related conditions. The two main types of bone marrow transplantation are Autologous and Allogeneic Hematopoietic Stem Cell Transplantation (HSCT).
Read More
Bone Marrow Aspiration and Biopsy are diagnostic procedures used to evaluate the health and functionality of the bone marrow—the soft, spongy tissue inside bones that produces blood cells.
Read More
Precise laboratory diagnosis of hematological disorders involves specialized tests and analyses conducted in clinical laboratories to detect, monitor, and manage diseases affecting the blood and bone marrow. Accurate identification of these conditions is essential for effective treatment and prognosis.
Read More
Genetic counseling for patients with blood disorders is a specialized process where trained healthcare professionals provide information, guidance, and support to individuals and families at risk of inherited blood conditions. It aims to help them understand the genetic aspects of the disorder, assess risks, and make informed decisions about their healthcare and family planning.
Read More
CAR-T cell therapy (Chimeric Antigen Receptor T-cell therapy) is an advanced and innovative form of immunotherapy used to treat certain types of cancers, especially blood cancers like leukemia and lymphoma.
Read More

